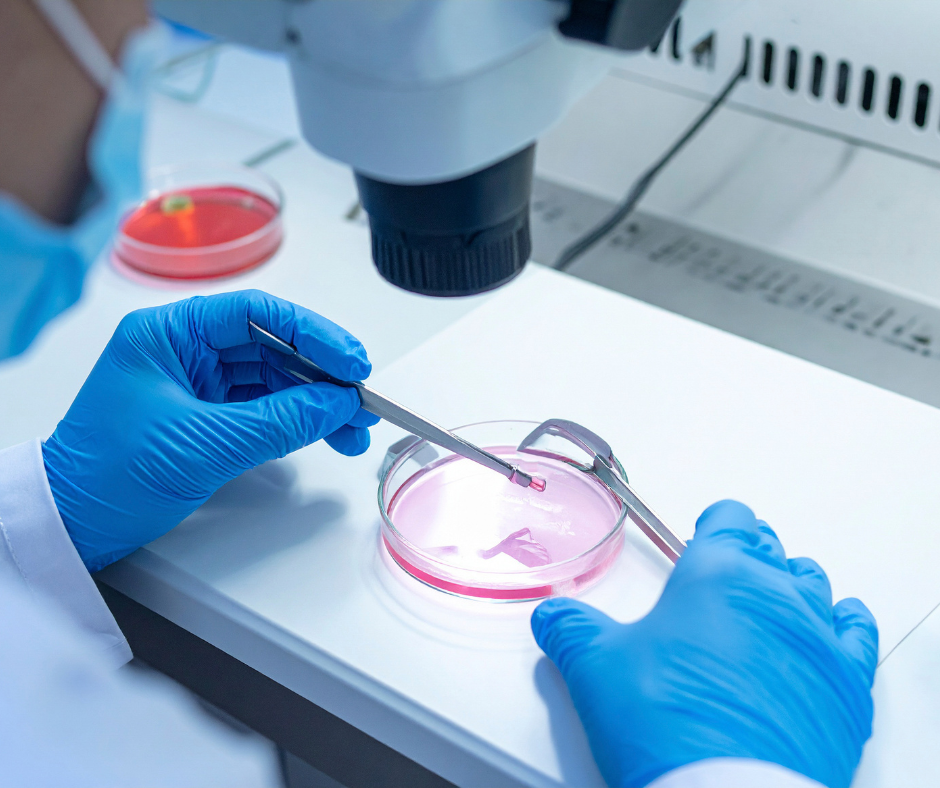

Discover why psychiatry and mental health support are essential during infertility treatment. Learn how emotional wellness improves outcomes and supports patients through the fertility journey.
Infertility can be one of the most emotionally challenging experiences a person or couple can face. Between medical appointments, uncertainty, financial strain, and the emotional toll of trying to conceive, the journey can feel overwhelming. That’s why psychiatry and mental health support play such a critical role in fertility care.
At Hudson Valley Fertility, we believe that fertility treatment should address the whole person—not just the physical aspects of reproduction. Emotional wellbeing, stress management, and psychological support are vital components of a healthy fertility journey. When mental health care is integrated with fertility treatment, patients are better equipped to navigate the ups and downs that often accompany infertility.
In this article, we’ll explore the importance of psychiatric and mental health support during fertility treatment, how it impacts wellness, and practical ways patients can protect their emotional health while pursuing parenthood.

Understanding the Emotional Impact of Infertility
Infertility is not just a medical condition; it is an emotional experience that can affect every area of life.
Many individuals describe infertility as a cycle of hope and disappointment. Each new treatment or attempt brings optimism, while negative results can bring grief, frustration, or anxiety.
Common emotional challenges include:
- Persistent stress and worry
- Feelings of isolation
- Depression or sadness
- Relationship strain
- Loss of control
- Emotional exhaustion
Research has shown that the psychological stress of infertility can be comparable to dealing with other major medical conditions. According to the American Society for Reproductive Medicine, emotional support is an essential part of comprehensive fertility care.
Without proper support, these emotional pressures can accumulate and affect mental health, relationships, and overall wellbeing.

Why Mental Health Support Is Essential During Fertility Treatment
Fertility treatments such as IVF, IUI, and hormone therapies can intensify emotional stress. Patients often face strict schedules, physical side effects, financial concerns, and uncertainty about outcomes.
Mental health professionals, including psychiatrists, psychologists, and fertility counselors, help patients navigate these challenges in healthy ways.
Key Benefits of Mental Health Support
- Stress management during treatment cycles
- Coping strategies for disappointment or setbacks
- Support for relationship communication
- Guidance through complex medical decisions
- Treatment for anxiety or depression
- Improved emotional resilience
Mental health care does not mean something is wrong; it means patients are taking proactive steps to protect their well-being during a demanding process.

The Role of Psychiatry in Fertility Care
Psychiatry plays a unique role in supporting fertility patients, particularly when emotional symptoms become severe or persistent.
Psychiatrists are medical doctors who specialize in diagnosing and treating mental health conditions. They can evaluate emotional symptoms and provide treatment options that may include therapy, lifestyle strategies, or medication when appropriate.
When Psychiatric Support May Be Helpful
Psychiatric care may benefit patients who experience:
- Severe anxiety about treatment outcomes
- Depression related to infertility struggles
- Sleep disturbances or burnout
- Difficulty functioning at work or in daily life
- Emotional trauma after pregnancy loss
- Increased stress affecting relationships
A psychiatrist also understands how mental health treatments interact with fertility medications and pregnancy planning, ensuring safe and coordinated care.
This collaboration between reproductive specialists and mental health professionals helps patients receive well-rounded, personalized care.

Balancing Work, Life, and Fertility Treatment
One of the most overlooked challenges of fertility treatment is managing it alongside professional responsibilities.
Appointments for monitoring, bloodwork, ultrasounds, and procedures often occur early in the morning or during work hours. Hormonal treatments can also cause fatigue, mood changes, and physical discomfort.
Many patients feel pressure to keep treatments private at work, which can increase stress and isolation.
Strategies for Managing Work During Treatment
Patients often find relief by adopting practical strategies such as:
- Planning appointments in advance when possible
- Communicating with trusted supervisors or HR representatives
- Using flexible scheduling or remote work options
- Prioritizing rest during demanding treatment phases
- Setting healthy work-life boundaries
Mental health professionals can help patients develop personalized coping strategies that allow them to balance career responsibilities with fertility care.
Supporting Emotional Wellness Throughout the Fertility Journey
Emotional wellness is not a one-time solution, it requires ongoing attention throughout the fertility journey.
Developing healthy routines and support systems can significantly improve resilience during treatment.
Helpful Wellness Practices
Some supportive practices include:
1. Therapy or Counseling
Talking with a fertility-informed therapist provides a safe space to process emotions, fears, and expectations.
2. Mindfulness and Stress Reduction
Meditation, yoga, and breathing techniques can help calm the nervous system and reduce anxiety.
3. Support Groups
Connecting with others experiencing infertility can reduce feelings of isolation.
4. Healthy Lifestyle Habits
Exercise, balanced nutrition, and adequate sleep support both mental and physical health.
5. Relationship Communication
Open conversations with partners can strengthen emotional support during treatment.
Even small lifestyle changes can help patients regain a sense of control and stability.
The Connection Between Mental Health and Fertility Outcomes
While mental health support cannot guarantee pregnancy success, it can significantly improve a patient’s overall experience during treatment.
High levels of chronic stress may affect hormone regulation, sleep patterns, and physical health. By addressing emotional wellbeing, patients may be better able to tolerate treatment cycles and maintain healthy routines.
More importantly, mental health care ensures that patients feel supported regardless of the outcome.
A fertility journey is not only about reaching a goal, it’s also about protecting the emotional health of individuals and couples along the way.
How Hudson Valley Fertility Supports Whole-Person Care
At Hudson Valley Fertility, we understand that fertility care extends beyond medical treatment. Our goal is to provide compassionate, patient-centered care that supports both physical and emotional wellbeing.
By encouraging mental health resources, counseling, and psychiatric support when needed, we help patients navigate infertility with resilience and confidence.
Our approach recognizes that emotional health is just as important as reproductive health. When patients feel supported, informed, and empowered, they are better prepared to face the challenges of fertility treatment.

Frequently Asked Questions
1. Is it normal to feel depressed or anxious during infertility treatment?
Yes. Infertility treatment can be emotionally demanding, and many individuals experience anxiety, sadness, or frustration. Seeking mental health support is a healthy and proactive step.
2. Should I see a psychiatrist during fertility treatment?
If emotional symptoms such as anxiety, depression, or sleep problems become overwhelming, a psychiatrist can provide specialized care and treatment options tailored to fertility patients.
3. Can stress affect fertility treatment outcomes?
Stress alone does not cause infertility, but chronic stress can affect overall health and emotional wellbeing. Managing stress helps patients better navigate the treatment process.
4. How can I manage work while undergoing fertility treatment?
Planning appointments, communicating with employers when comfortable, and setting realistic expectations can help balance work and treatment responsibilities.
5. Are fertility counseling services common?
Yes. Many fertility clinics encourage counseling because emotional support improves patients’ ability to cope with treatment challenges.
6. How can partners support each other during infertility?
Open communication, empathy, shared decision-making, and attending counseling together can strengthen relationships during the fertility journey.
Conclusion
Infertility treatment is more than a medical process; it is an emotional journey that affects every aspect of life. Psychiatry and mental health support provide essential tools for navigating the stress, uncertainty, and challenges that can arise along the way.
By prioritizing emotional wellness, patients can approach fertility treatment with greater resilience, clarity, and support.
At Hudson Valley Fertility, we believe that caring for mental health is a vital part of fertility care. When emotional and physical health are addressed together, patients are empowered to move forward with strength, hope, and confidence.